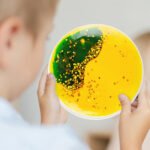
Sensory Colourful Liquid Round Mat – Set of 6 - Image 4
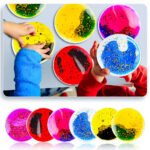
Sensory Colourful Liquid Round Mat – Set of 6 - Image 5

Sensory Colourful Liquid Round Mat – Set of 6
$25.00
Sensory Colourful Liquid Round Mats – Set of 6
Bring colour, calm, and curiosity to sensory play with these vibrant liquid-filled round mats. Each disc contains mesmerising, slow-moving liquids that swirl and blend with gentle pressure, offering a captivating tactile and visual experience. Perfect for sensory exploration, mindfulness, and STEM-inspired discussions about colour mixing and movement.
Ideal for early learning environments, therapy rooms, and quiet corners, these mats promote focus, emotional regulation, and creative discovery. Children can press, tilt, and observe as the shimmering colours and glitter flow within each disc — encouraging hands-on exploration and sensory awareness.
Product Details:
-
Set of 6 sensory discs (red, blue, yellow, pink, green, and multi-colour)
-
Filled with non-toxic, sealed liquid and glitter for safe, mess-free play
-
Encourages sensory engagement, hand-eye coordination, and observation skills
-
Ideal for tabletops, light tables, or floor play
-
Easy to clean and durable for repeated use
-
Recommended age: 3+ years
EYLF Learning Connections
-
Outcome 1 – Identity: Encourages calmness and self-regulation through sensory play.
-
Outcome 3 – Wellbeing: Supports sensory needs and fine motor development.
-
Outcome 4 – Learning: Inspires curiosity, observation, and scientific exploration.
-
Outcome 5 – Communication: Promotes language as children describe colours and movement.

Reviews
There are no reviews yet.